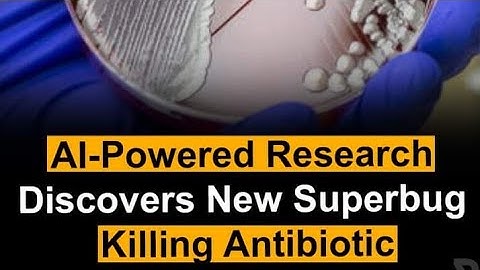
AI Powered Research Discover new Superbugs Killing Antibiotics

⬇ DOWNLOAD NOW
Kalau muncul iklan pop-up, tutup lalu klik tombol kembali
Download lagu New superbug-killing antibiotic discovered using AI secara gratis hanya untuk keperluan promosi. Dukung artis favorit kamu dengan membeli musik original di iTunes atau platform resmi lainnya.
 New superbug killing antibiotic discovered using AI
New superbug killing antibiotic discovered using AI
 New superbug-killing antibiotic discovered using AI
New superbug-killing antibiotic discovered using AI
 New Superbug-killing antibiotic discovered | Latest World News | English News | WION
New Superbug-killing antibiotic discovered | Latest World News | English News | WION
AI Powered Research Discover new Superbugs Killing Antibiotics
AI Powered Research Discover new Superbugs Killing Antibiotics
 AI to create a superbug-killing antibiotic | 7NEWS
AI to create a superbug-killing antibiotic | 7NEWS
 Revolutionary AI Discovery: Promising Antibiotic Unveiled to Tackle Deadly Superbugs
Revolutionary AI Discovery: Promising Antibiotic Unveiled to Tackle Deadly Superbugs
 New Superbug Killer Discovered: Powerful Antibiotic Hiding in Plain Sight for Decades
New Superbug Killer Discovered: Powerful Antibiotic Hiding in Plain Sight for Decades
 STRONG ANTIBIOTIC = SUPERBUG
STRONG ANTIBIOTIC = SUPERBUG